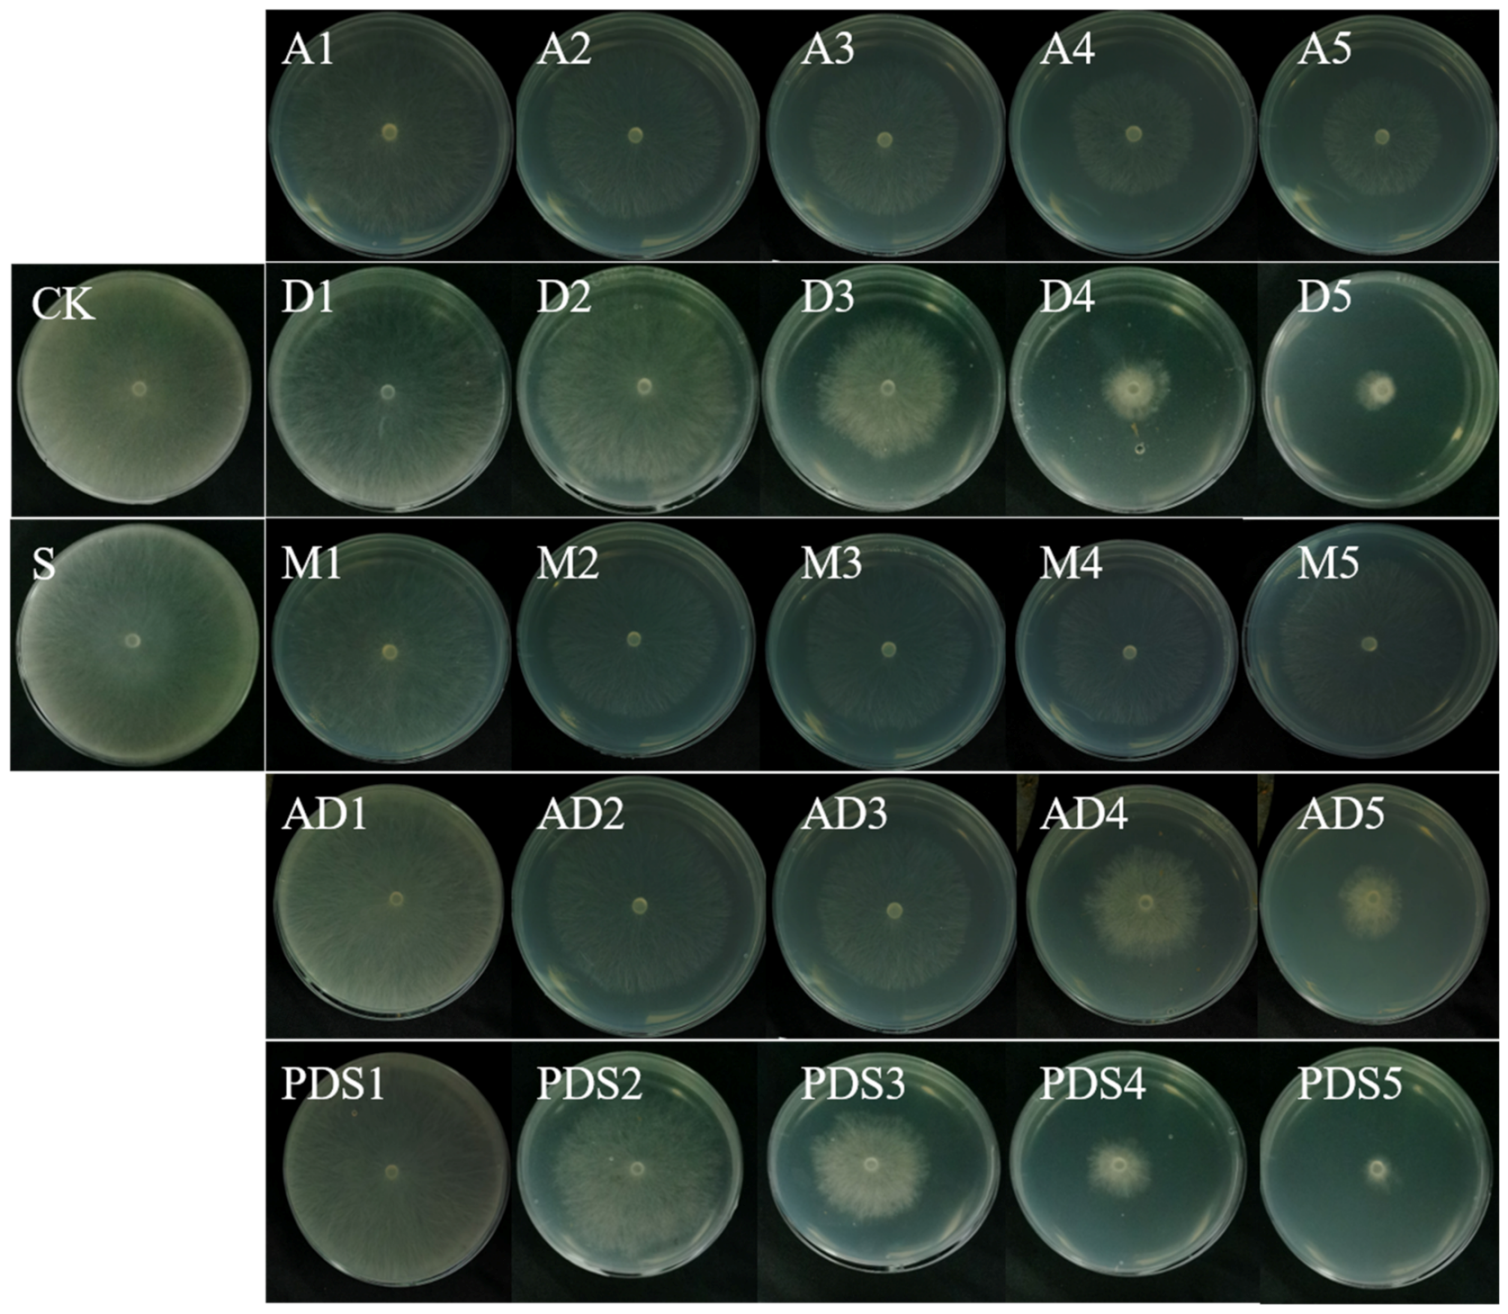
Ijms 22 10412 g008

Enhanced Fungicidal Efficacy by Co-Delivery of Azoxystrobin and Diniconazole with Cauliflower-Like Metal–Organic Frameworks NH2-Al-MIL-101
Abstract
:1. Introduction
2. Results and Discussion
2.1. Sample Preparation and Characterization
2.2. Optimization of the Loading Content and Encapsulation Efficiency
2.3. Controlled Release of AZOX and Dini
2.4. In Vitro Antifungal Activity Assay
3. Materials and Methods
3.1. Materials
3.2. Synthesis of the Particles
3.2.1. Synthesis of NH2-Al-MIL-101 Crystals
3.2.2. Preparation of AZOX@Dini@NH2-Al-MIL-101 Crystals
3.3. Characterizations of Samples
3.4. In Vitro Release of AZOX and Dini
3.5. Bioactivity Studies of the Samples
3.6. Statistical Analysis
4. Conclusions
Author Contributions
Funding
Institutional Review Board Statement
Informed Consent Statement
Data Availability Statement
Conflicts of Interest
References
- Lee, F.N. Rice Sheath Blight: A Major Rice Disease. Plant Dis. 1983, 67, 829–832. [Google Scholar] [CrossRef]
- Singh, P.; Mazumdar, P.; Harikrishna, J.A.; Babu, S. Sheath blight of rice: A review and identification of priorities for future research. Planta 2019, 250, 1387–1407. [Google Scholar] [CrossRef] [PubMed] [Green Version]
- Molla, K.A.; Karmakar, S.; Molla, J.; Bajaj, P.; Varshney, R.K.; Datta, S.K.; Datta, K. Understanding sheath blight resistance in rice: The road behind and the road ahead. Plant Biotechnol. J. 2020, 18, 895–915. [Google Scholar] [CrossRef] [PubMed]
- Ou, S.H. Rice Diseases, 2nd ed.; Commonwealth Mycological Institute: Kew, UK, 1985; pp. 109–201. [Google Scholar]
- Green, D.E.; Burpee, L.L.; Stevenson, K.L. Components of Resistance to Rhizoctonia solani Associated with Two Tall Fescue Cultivars. Plant Dis. 1999, 83, 834–838. [Google Scholar] [CrossRef] [PubMed] [Green Version]
- Kannaiyan, S.; Prasad, N.N. Effect of spacing on the spread of sheath blight disease of rice. Madras Agric. J. 1983, 70, 135–136. [Google Scholar]
- Marchetti, M.A.; Bollich, C.N. Quantification of the relationship between sheath blight severity and yield loss in rice. Plant Dis. 1991, 75, 773–775. [Google Scholar] [CrossRef]
- Marchetti, M.A. Potential Impact of Sheath Blight on Yield and Milling Quality of Short-Statured Rice Lines in the Southern United States. Plant Dis. 1983, 67, 162–165. [Google Scholar] [CrossRef]
- Groth, D.E. Effects of cultivar resistance and single fungicide application on rice sheath blight, yield, and quality. Crop Prot. 2008, 27, 1125–1130. [Google Scholar] [CrossRef]
- Chaudhary, S.; Sagar, S.; Lal, M. A comprehensive overview on sheath blight disease of rice and its management. Agricultura 2019, 28, 145–174. [Google Scholar]
- Uppala, S.; Zhou, X.G. Field efficacy of fungicides for management of sheath blight and narrow brown leaf spot of rice. Crop Prot. 2018, 104, 72–74. [Google Scholar] [CrossRef]
- Chen, Y.; Zhang, A.F.; Wang, W.X.; Zhang, Y.; Gao, T.C. Baseline sensitivity and efficacy of thifluzamide in Rhizoctonia solani. Ann. Appl. Biol. 2012, 161, 247–254. [Google Scholar] [CrossRef]
- Kabir, M.H.; Islam, S.M.A.; Sultana, N.; Azad, M.A.K.; Fakir, G.A. Effect of seed cleaning, washing and treating with Vitavax on incidence and severity of Boro rice diseases. Int. J. Sustain. Agric. Technol. 2006, 2, 27–31. [Google Scholar]
- Chia, T.H. Hexaconazole (Anvil 5SC) a broad spectrum systemic fungicide for disease control in some plantation crops. Planter 1997, 73, 129–135. [Google Scholar]
- Bag, M.K.; Yadav, M.; Mukherjee, A.K. Bioefficacy of strobilurin based fungicides against rice sheath blight disease. Transcriptomics 2016, 4, 2. [Google Scholar]
- Kumar, P.; Ahlawat, S.; Chauhan, R.; Kumar, A.; Singh, R.; Kumar, A. In vitro and field efficacy of fungicides against sheath blight of rice and post-harvest fungicide residue in soil, husk, and brown rice using gas chromatography-tandem mass spectrometry. Environ. Monit. Assess. 2018, 190, 503. [Google Scholar] [CrossRef]
- Ichiba, T.; Kumano, K.; Kashino, H.; Nanba, K.; Mizutani, A.; Miki, N. Effect of metominostrobin on respiratory activity of rhizoctonia solani and its efficacy for controlling rice sheath blight. J. Pestic. Sci. 2000, 25, 398–401. [Google Scholar] [CrossRef] [Green Version]
- Singh, R.; Sunder, S.; Dodan, D.S. Standardization of inoculation method in nursery beds and management of sheath blight of rice through host resistance, chemicals and botanicals. Indian Phytopathol. 2010, 63, 286–291. [Google Scholar]
- Yuji, F.; Yukio, I.; Toshiro, K.; Shizuya, T. Structure-activity relationships of vinyl triazole fungicides. J. Pestic. Sci. 1984, 9, 229–236. [Google Scholar]
- Takano, H.; Oguri, Y.; Kato, T. Mode of Action of (E)-1-(2, 4-dichlorophenyl)-4, 4-dimethyl-2-(1, 2, 4-triazol-1-yl)-1-penten-3-ol (S-3308) in Ustilago maydis. J. Pestic. Sci. 1983, 8, 575–582. [Google Scholar] [CrossRef] [Green Version]
- Xu, C.L.; Cao, L.D.; Zhao, P.Y.; Zhou, Z.L.; Cao, C.; Zhu, F.; Li, F.M.; Huang, Q.L. Synthesis and Characterization of Stimuli-Responsive Poly(2-dimethylamino-ethylmethacrylate)-Grafted Chitosan Microcapsule for Controlled Pyraclostrobin Release. Int. J. Mol. Sci 2018, 19, 854. [Google Scholar] [CrossRef] [PubMed] [Green Version]
- Mattos, B.D.; Tardy, B.L.; Magalhães, W.L.E.; Rojas, O.J. Controlled release for crop and wood protection: Recent progress toward sustainable and safe nanostructured biocidal systems. J. Control. Release 2017, 262, 139–150. [Google Scholar] [CrossRef] [PubMed]
- Vikrant, K.; Tsang, D.C.W.; Raza, N.; Giri, B.S.; Kukkar, D.; Kim, K.H. Potential utility of metal-organic framework-based platform for sensing pesticides. ACS Appl. Mater. Interfaces 2018, 10, 8797–8817. [Google Scholar] [CrossRef] [PubMed]
- Meng, W.; Tian, Z.; Yao, P.; Fang, X.; Zou, A. reparation of a novel sustained-release system for pyrethroids by using metal-organic frameworks (MOFs) nanoparticle. Colloids Surf. A 2020, 604, 125266. [Google Scholar] [CrossRef]
- Tang, J.Y.; Ding, G.L.; Niu, J.F.; Zhang, W.B.; Tang, G.; Liang, Y.; Fan, C.; Dong, H.Q.; Yang, J.L.; Li, J.Q.; et al. Preparation and characterization of tebuconazole metal-organic framework-based microcapsules with dual-microbicidal activity. Chem. Eng. J. 2019, 359, 225–232. [Google Scholar] [CrossRef]
- Tang, J.Y.; Tang, G.; Niu, J.F.; Yang, J.L.; Zhou, Z.Y.; Gao, Y.H.; Chen, X.; Tian, Y.Y.; Li, Y.; Li, J.Q.; et al. Preparation of a porphyrin metal–organic framework with desirable photodynamic antimicrobial activity for sustainable plant disease management. J. Agric. Food Chem. 2021, 69, 2382–2391. [Google Scholar] [CrossRef] [PubMed]
- Pi, Y.H.; Li, X.Y.; Xia, Q.B.; Wu, J.L.; Li, Y.W.; Xiao, J.; Li, Z. Adsorptive and photocatalytic removal of persistent organic pollutants (POPs) in water by metal-organic frameworks (MOFs). Chem. Eng. J. 2018, 337, 351–371. [Google Scholar] [CrossRef]
- Shan, Y.P.; Cao, L.D.; Muhammad, B.; Xu, B.; Zhao, P.Y.; Cao, C.; Huang, Q.L. Iron-based porous metal-organic frameworks with crop nutritional function as carriers for controlled fungicide release. J. Colloid Interface Sci. 2020, 566, 383–393. [Google Scholar] [CrossRef]
- Shan, Y.P.; Xu, C.L.; Zhang, H.J.; Chen, H.P.; Muhammad, B.; Niu, S.J.; Cao, L.D.; Huang, Q.L. Polydopamine-modified metal–organic frameworks, NH2-Fe-MIL-101, as pH-sensitive nanocarriers for controlled pesticide release. Nanomaterials 2020, 10, 2000. [Google Scholar] [CrossRef]
- Maluin, F.N.; Hussein, M.Z.; Yusof, N.A.; Fakurazi, S.; Abu Seman, I.; Hilmi, N.H.Z.; Daim, L.D.J. Enhanced fungicidal efficacy on Ganoderma boninense by simultaneous co-delivery of hexaconazole and dazomet from their chitosan nanoparticles. Plant Dis. 2019, 9, 27083–27095. [Google Scholar] [CrossRef] [Green Version]
- Perry, J.J., IV; Bauer, C.A.; Allendorf, M.D. Luminescent metal-organic frameworks. Met. Fram. Appl. Catal Gas. Storage 2011, 19, 267–308. [Google Scholar]
- Ryu, U.; Jee, S.; Rao, P.C.; Shin, J.; Ko, C.; Yoon, M.; Park, K.S.; Choi, K.M. Recent advances in process engineering and upcoming applications of metal-organic frameworks. Coord. Chem. Rev. 2021, 426, 213544. [Google Scholar] [CrossRef]
- Lu, T.; Zhang, L.C.; Sun, M.X.; Deng, D.Y.; Su, Y.Y.; Lv, Y. Amino-functionalized metal-organic frameworks nanoplates-based energy transfer probe for highly selective fluorescence detection of free chlorine. Anal. Chem. 2016, 88, 3413–3420. [Google Scholar] [CrossRef]
- Yin, H.Q.; Yang, J.C.; Yin, X.B. Ratiometric fluorescence sensing and real-time detection of water in organic solvents with one-pot synthesis of Ru@MIL-101(Al)-NH2. Anal. Chem. 2017, 89, 13434–13440. [Google Scholar] [CrossRef]
- Schubert, M.; Mueller, U.; Kiener, C. Aluminum Aminocarboxylates as Porous Metal Organic Frameworks. U.S. Patent US8313559 B2, 20 November 2012. [Google Scholar]
- Hinterholzinger, F.M.; Ruhle, B.; Wuttke, S.; Karaghiosoff, K.; Bein, T. Highly sensitive and selective fluoride detection in water through fluorophore release from a metal-organic framework. Sci. Rep. 2013, 3, 2562. [Google Scholar] [CrossRef]
- Toyao, T.; Fujiwaki, M.; Horiuchi, Y.; Matsuoka, M. Application of an amino-functionalised metal-organic framework: An approach to a one-pot acid-base reaction. RSC Adv. 2013, 3, 21582–21587. [Google Scholar] [CrossRef]
- Seoane, B.; Tellez, C.; Coronas, J.; Staudt, C. NH2-MIL-53(Al) and NH2-MIL-101(Al) in sulfur-containing copolyimide mixed matrix membranes for gas separation. Sep. Purif. Technol. 2013, 111, 72–81. [Google Scholar] [CrossRef]
- Thommes, M. Physical adsorption characterization of nanoporous materials. Chem. Ing. Tech. 2010, 82, 1059–1073. [Google Scholar] [CrossRef]
- Wittmann, T.; Siegel, R.; Reimer, N.; Milius, W.; Stock, N.; Senker, J. Enhancing the water stability of Al-MIL-101-NH2 via postsynthetic modification. Chem. Eur. J. 2015, 21, 314–323. [Google Scholar] [CrossRef] [PubMed]
- Taha, A.A.; Huang, L.; Ramakrishna, S.; Liu, Y. MOF [NH2-MIL-101(Fe)] as a powerful and reusable fenton-like catalyst. Journal of Water Process Engineering. Transcriptomics. 2016, 4, 2. [Google Scholar]
- Kumar, P.; Deep, A.; Kim, K.H.; Staudt, C. Metal organic frameworks for sensing applications. Trends Anal. Chem. 2015, 73, 39–53. [Google Scholar] [CrossRef]
- Horcajada, P.; Serre, C.; Maurin, G.; Ramsahye, N.A.; Balas, F.; Vallet-Regi, M.; Sebban, M.; Taulelle, F.; Ferey, G. Flexible porous metal organic frameworks for a controlled drug delivery. J. Am. Chen. Soc. 2008, 130, 6774–6780. [Google Scholar] [CrossRef]
- Zhao, P.Y.; Cao, L.D.; Ma, D.K.; Zhou, Z.L.; Huang, Q.L.; Pan, C.P. Translocation, distribution and degradation of prochloraz-loaded mesoporous silica nanoparticles in cucumber plants. Nanoscale 2018, 10, 1798–1806. [Google Scholar] [CrossRef] [PubMed]
- Bruneau, M.; Bennici, S.; Brendle, J.; Dutournie, P.; Limousy, L.; Pluchon, S. Systems for stimuli-controlled release: Materials and applications. J. Control. Release 2018, 294, 355–371. [Google Scholar] [CrossRef] [PubMed]
- Peng, H.L.; Xiong, H.; Li, J.H.; Xie, M.Y.; Liu, Y.Z.; Bai, C.Q.; Chen, L.X. Vanillin cross-linked chitosan microspheres for controlled release of resveratrol. Food Chem. 2010, 121, 23–28. [Google Scholar] [CrossRef]
- Ritger, P.L.; Peppas, N.A. A simple equation for description of solute release I. Fickian and non-Fickian release from non-swellable devices in the form of slabs, spheres, cylinders or discs. J. Control. Release 1987, 5, 23–36. [Google Scholar] [CrossRef]
- Ritger, P.L.; Peppas, N.A. A simple equation for description of solute release II. Fickian and anomalous release from swellable devices. J. Control. Release 1987, 5, 37–42. [Google Scholar] [CrossRef]
- Erwin, D.C.; Ribeiro, O.K. Introduction to the genus Phytophthora. In Phytophthora Diseases Worldwide; Erwin, D.C., Ribeiro, O.K., Eds.; The American Phytopathological Society: St. Paul, MN, USA, 1996; pp. 1–7. [Google Scholar]
- Kumar, P.; Kumar, A.; Singh, R. Integrated management of rhizoctonia solani causing sheath blight of rice (Oryza sativa). Indian J. Agric. Sci. 2019, 89, 2079–2084. [Google Scholar]
- Aziz, A.; Badr, I.; El-Sayed, I. Synthesis, spectroscopic, photoluminescence properties and biological evaluation of novel Zn(II) and Al(III) complexes of NOON tetradentate schiff bases. Spectrochim. Acta Part A 2012, 97, 388–396. [Google Scholar] [CrossRef]
- Gisi, U. Synergistic interaction of fungicides in mixtures. Phytopathology 1996, 86, 1273–1279. [Google Scholar]
- Lore, J.S.; Hunjan, M.S. Bioefficacy of azoxystrobin and metominostrobin against sheath blight of rice. Plant Dis. Res. 2012, 27, 81–83. [Google Scholar]
- Isaeva, V.I.; Tarasov, A.L.; Starannikova, L.E.; Yampolśkii, Y.P.; Alentév, A.Y.; Kustov, L.M. Microwaveassisted synthesis of mesoporous metalorganic framework NH2-MIL-101(Al). Russ. Chem. Bull. 2015, 64, 2791–2795. [Google Scholar] [CrossRef]
- Serra-Crespo, P.; Ramos-Fernandez, E.V.; Gascon, J.; Kapteijn, F. Synthesis and Characterization of an Amino Functionalized MIL-101(Al): Separation and Catalytic Properties. Chem. Mater. 2011, 23, 2565–2572. [Google Scholar] [CrossRef]
- Liang, W.L.; Xie, Z.G.; Cheng, J.L.; Xiao, D.X.; Xiong, Q.Y.; Wang, Q.W.; Zhao, J.H.; Cui, W.J. A light-triggered pH-responsive metal-organic framework for smart delivery of fungicide to control sclerotinia diseases of oilseed rape. ACS Nano 2021, 15, 6987–6997. [Google Scholar] [CrossRef] [PubMed]

| Samples | SBET (m2/g) | Vt (cm3/g) | DBJH (nm) |
|---|---|---|---|
| NH2-Al-MIL-101 | 2359.0 | 1.36 | 2.30 |
| AZOX@Dini@NH2-Al-MIL-101 | 468.7 | 0.32 | 2.73 |
| Entry | Carrier Material | Pesticide | LC (%) | EE (%) |
|---|---|---|---|---|
| Entry 1 | NH2-Al-MIL-101 | AZOX | 7.28 ± 0.34 | 9.17 ± 0.42 |
| Entry 2 | NH2-Al-MIL-101 | Dini | 29.79 ± 0.67 | 42.99 ± 0.97 |
| Entry 3 | NH2-Al-MIL-101 | AZOX | 6.71 ± 0.46 | 7.19 ± 0.53 |
| Dini | 29.72 ± 0.29 | 42.24 ± 0.59 |
| pH | Fitting Model | AZOX | Dini | ||
|---|---|---|---|---|---|
| Kinetic Equation | R2 | Kinetic Equation | R2 | ||
| 3.0 | Zero-order | y = 50.86 + 1.28t | 0.5390 | y = 11.95 + 0.60t | 0.9798 |
| First-order | y = 87.53 × (1−e(−0.31t)) | 0.9814 | y = 110.11 × (1 − e(−0.01t)) | 0.9854 | |
| Korsmeyer–Peppas | y = 39.61 × (t0.25) | 0.8485 | y = 3.45 × (t0.66) | 0.9946 | |
| Higuchi | y = 11.18 × (t1/2) + 31.54 | 0.7408 | y = 8.02 × (t1/2) −8.80 | 0.9812 | |
| 7.1 | Zero-order | y = 68.91 + 0.93t | 0.3445 | y = 25.33 + 0.62t | 0.7980 |
| First-order | y = 95.62 × (1−e(−0.49t)) | 0.9846 | y = 94.27 × (1 − e(−0.03t) | 0.9961 | |
| Korsmeyer–Peppas | y = 56.52 × (t0.17) | 0.9677 | y = 10.37 × (t0.46) | 0.9447 | |
| Higuchi | y = 8.65 × (t1/2) + 52.92 | 0.7384 | y = 895 × (t1/2) −0.40 | 0.9414 | |
| 10.1 | Zero-order | y = 38.27 + 0.66t | 0.3360 | y = 14.13 + 0.70t | 0.9312 |
| First-order | y = 57.76 × (1 − e(−0.40t)) | 0.9922 | y = 112.41 × (1 − e(−0.01t)) | 0.9928 | |
| Korsmeyer–Peppas | y = 30.37 × (t0.20) | 0.7027 | y = 4.63 × (t0.63) | 0.9793 | |
| Higuchi | y = 6.16 × (t1/2) + 26.89 | 0.5453 | y = 9.48 × (t1/2) −11.26 | 0.9810 | |
| Fungicides | Toxicity Regression Equation | Correlation Coefficient | EC50(ob) (mg/mL) | EC50(th) (mg/mL) | Synergistic Ration |
|---|---|---|---|---|---|
| AZOX | y = −0.04 + 0.49x | 0.904 | 1.251 | − | − |
| Dini | y = 1.53 + 1.56x | 0.984 | 0.099 | − | − |
| AD | y = 0.89 + 0.85x | 0.998 | 0.087 | 0.1187 | 1.36 |
| PDS | y = 1.17 + 0.98x | 0.994 | 0.065 | 0.1192 | 1.83 |
Publisher’s Note: MDPI stays neutral with regard to jurisdictional claims in published maps and institutional affiliations. |
© 2021 by the authors. Licensee MDPI, Basel, Switzerland. This article is an open access article distributed under the terms and conditions of the Creative Commons Attribution (CC BY) license (https://creativecommons.org/licenses/by/4.0/).
Share and Cite
Chen, H.; Shan, Y.; Cao, L.; Zhao, P.; Cao, C.; Li, F.; Huang, Q. Enhanced Fungicidal Efficacy by Co-Delivery of Azoxystrobin and Diniconazole with Cauliflower-Like Metal–Organic Frameworks NH2-Al-MIL-101. Int. J. Mol. Sci. 2021, 22, 10412. https://doi.org/10.3390/ijms221910412
Chen H, Shan Y, Cao L, Zhao P, Cao C, Li F, Huang Q. Enhanced Fungicidal Efficacy by Co-Delivery of Azoxystrobin and Diniconazole with Cauliflower-Like Metal–Organic Frameworks NH2-Al-MIL-101. International Journal of Molecular Sciences. 2021; 22(19):10412. https://doi.org/10.3390/ijms221910412
Chicago/Turabian StyleChen, Huiping, Yongpan Shan, Lidong Cao, Pengyue Zhao, Chong Cao, Fengmin Li, and Qiliang Huang. 2021. "Enhanced Fungicidal Efficacy by Co-Delivery of Azoxystrobin and Diniconazole with Cauliflower-Like Metal–Organic Frameworks NH2-Al-MIL-101" International Journal of Molecular Sciences 22, no. 19: 10412. https://doi.org/10.3390/ijms221910412
APA StyleChen, H., Shan, Y., Cao, L., Zhao, P., Cao, C., Li, F., & Huang, Q. (2021). Enhanced Fungicidal Efficacy by Co-Delivery of Azoxystrobin and Diniconazole with Cauliflower-Like Metal–Organic Frameworks NH2-Al-MIL-101. International Journal of Molecular Sciences, 22(19), 10412. https://doi.org/10.3390/ijms221910412







